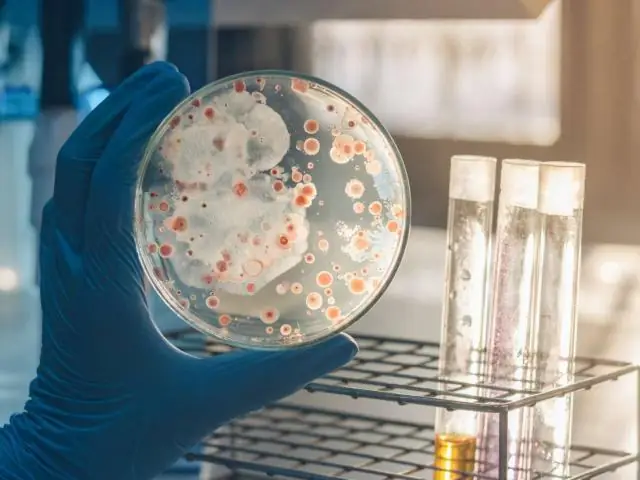
Как бактерии выживают при лечении антибиотиками

Мультирезистентные бактерии Ученые всего мира прилагают все усилия, чтобы победить в битве с полирезистентными бактериями. В новой публикации Центра BASP Университета Копенгагена показано, как даже чувствительным бактериям часто удается выжить при лечении антибиотиками в виде так называемых «клеток-персистеров». Всесторонний взгляд на это явление может помочь улучшить существующие варианты медикаментозного лечения и даже вдохновить на открытие новых антибиотиков, нацеленных на эти заведомо трудно поддающиеся лечению персистирующие бактерии.
В текущем выпуске журнала Science Александр Хармс и его коллеги из Центра BASP кафедры биологии Копенгагенского университета обобщают недавно открытые молекулярные механизмы, объясняющие, как бактериям удается выживать при лечении антибиотиками и вызывать хронические и рецидивирующие инфекции.
Пост-док Александр Хармс объясняет: «Эта удивительная устойчивость часто возникает из-за гибернации в физиологическом состоянии, называемом персистенцией, когда бактерии устойчивы ко многим антибиотикам и другим стрессовым факторам. Бактериальные клетки могут переключаться в персистенцию, активируя специальные физиологические программы. которые буквально отключают важные клеточные процессы. Как только они становятся персистентными, бактерии могут пережить даже длительную антибактериальную терапию и могут реанимировать, вызывая рецидивирующие инфекции в любое время после прекращения лечения».
Используя новые методы обнаружения, недавняя работа в этой области раскрыла молекулярную архитектуру нескольких клеточных путей, лежащих в основе образования бактериальных персистеров, и эти результаты подтвердили давнее представление о том, что персистенция тесно связана с медленным ростом или состоянием покоя.. Таким образом, устойчивость бактерий можно сравнить с зимней спячкой животных или устойчивыми спорами, образуемыми многими грибами и растениями.
У многих различных бактерий эти программы контролируются регулирующим соединением, известным как «волшебное пятно», которое играет центральную роль в феномене персистенции. Эти важные открытия, многие из которых были сделаны Центром BASP, могут в будущем способствовать разработке усовершенствованных схем медикаментозного лечения и в конечном итоге привести к разработке новых антибиотиков.